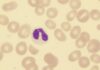
Study: Lower Educational Attainment Is Barrier to HCT for Patients with AML
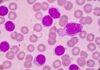
Zanubrutinib Shows Sustained Progression-Free Survival at Five Years
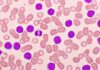
AMPLIFY Trial Reports Results of Acalabrutinib-Venetoclax in TN-CLL

ASH 2024
The 66th American Society of Hematology (ASH) Annual Meeting and Exposition is taking place in San Diego, California, and online from December 7–10, 2024. The meeting offers comprehensive education about hematologic topics and publishes thousands of scientific abstracts highlighting the latest findings in the field.
Day 1
Day 2
Day 3
Advertisement